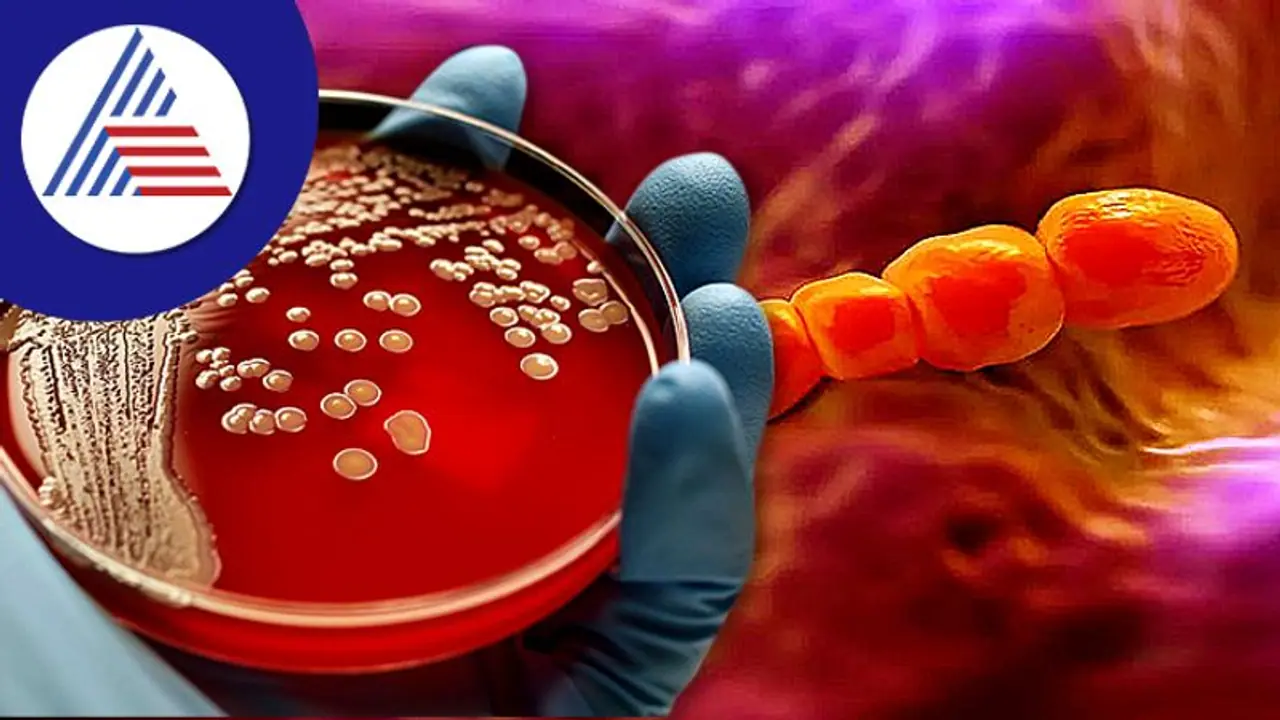
ಮಾರಕ ಕಾಯಿಲೆಗೆ ಕಾರಣವಾಗೋ ಐದು ಬ್ಯಾಕ್ಟಿರೀಯಾ; ಎಲ್ಲೆಲ್ಲಿ ಇರುತ್ತವೆ ತಿಳ್ಕೊಳ್ಳಿ ಮಾರಕ ಕಾಯಿಲೆಗೆ ಕಾರಣವಾಗೋ ಐದು ಬ್ಯಾಕ್ಟಿರೀಯಾ; ಎಲ್ಲೆಲ್ಲಿ ಇರುತ್ತವೆ ತಿಳ್ಕೊಳ್ಳಿ

ಬ್ಯಾಕ್ಟೀರಿಯಾಗಳು ತುಂಬಾ ಚಿಕ್ಕದಾಗಿದ್ದು ಅವು ಬರಿಗಣ್ಣಿಗೆ ಗೋಚರಿಸುವುದಿಲ್ಲ. ಆದರೆ ಕಣ್ಣಿಗೆ ಕಾಣದಷ್ಟು ಚಿಕ್ಕ ರೂಪದಲ್ಲಿದ್ದರೂ ಅವು ಆರೋಗ್ಯಕ್ಕೆ ಅತ್ಯಂತ ಅಪಾಯಕಾರಿ. ಅಂಥಾ ಬ್ಯಾಕ್ಟಿರೀಯಾಗಳು ಯಾವುವು ? ಅವುವು ಎಲ್ಲೆಲ್ಲಿ ಇರುತ್ತವೆ ತಿಳ್ಕೊಳ್ಳೋಣ.
ಬ್ಯಾಕ್ಟೀರಿಯಾಗಳು ತುಂಬಾನೇ ಡೇಂಜರಸ್. ಕಣ್ಣಿಗೆ ಕಾಣದಿದ್ದರೂ ಅದೆಷ್ಟೋ ಮಾರಕ ಕಾಯಿಲೆಗೆ (Disease) ಕಾರಣವಾಗಿ ಸಾವು-ನೋವಿಗೂ ಕಾರಣವಾಗುತ್ತವೆ. ದಿ ಲ್ಯಾನ್ಸೆಟ್ ಎಂಬ ವಿಜ್ಞಾನ ಪತ್ರಿಕೆಯಲ್ಲಿ ಅಧ್ಯಯನ (Study)ವೊಂದು ಪ್ರಕಟವಾಗಿದ್ದು, ಭಾರತದಲ್ಲಿ 6.8 ಲಕ್ಷ ಸಾವಿಗೆ ಕಾರಣವಾಗುವ 5 ಬ್ಯಾಕ್ಟೀರಿಯಾಗಳ ಹೆಸರನ್ನು ಇದರಲ್ಲಿ ಉಲ್ಲೇಖಿಸಲಾಗಿದೆ. ಈ ಬ್ಯಾಕ್ಟೀರಿಯಾಗಳು E. ಕೋಲಿ, S. ಔರಿಯಸ್, A. Baumaniani, S. ನ್ಯುಮೋನಿಯಾ ಮತ್ತು K. ನ್ಯುಮೋನಿಯಾವನ್ನು ಹೊಂದಿವೆ. ಅವು ಎಲ್ಲಿ ವಾಸಿಸುತ್ತಿದ್ದವು ಎಂಬುದನ್ನು ಬಹಿರಂಗಪಡಿಸಿದೆ.
2019ರಲ್ಲಿ, ಭಾರತದಲ್ಲಿ ಸುಮಾರು 6.8 ಲಕ್ಷ ಜನರ ಸಾವಿಗೆ (Death) ಬ್ಯಾಕ್ಟಿರೀಯಾ ಕಾರಣವಾಗಿದೆ. ವಿಜ್ಞಾನ ಜರ್ನಲ್ ದಿ ಲ್ಯಾನ್ಸೆಟ್ನ ಅಧ್ಯಯನದ ಪ್ರಕಾರ, ಈ ಸಾವುಗಳಿಗೆ 5 ಬ್ಯಾಕ್ಟೀರಿಯಾಗಳು ಪ್ರಮುಖ ಕಾರಣವಾಗಿವೆ. ಈ ಬ್ಯಾಕ್ಟೀರಿಯಾದ ಸೋಂಕುಗಳಿಗೆ ಔಷಧಿಗಳು ನಿಷ್ಪರಿಣಾಮಕಾರಿಯಾಗುತ್ತಿವೆ. ಸೋಂಕಿನ ನಂತರ ಸಾವಿನ ಅಪಾಯವು (Danger) ಹೆಚ್ಚಾಗುತ್ತದೆ ಎಂದು ತಿಳಿದುಬಂದಿದೆ. ಬ್ಯಾಕ್ಟೀರಿಯಾದ ಸೋಂಕಿನ ಔಷಧಿ (Medicine) ಏಕೆ ನಿಷ್ಪರಿಣಾಮಕಾರಿಯಾಗಿದೆ ? ಕಾಲಾನಂತರದಲ್ಲಿ ಬ್ಯಾಕ್ಟೀರಿಯಾಗಳು ತಮ್ಮ ರೂಪವನ್ನು ಬದಲಾಯಿಸಿಕೊಂಡಿವೆ. ಇವುಗಳಲ್ಲಿ ಅನೇಕ ರೀತಿಯ ರೂಪಾಂತರಗಳು ಸಂಭವಿಸಿವೆ. ರೂಪಾಂತರದ ನಂತರ, ಈಗಾಗಲೇ ಅಸ್ತಿತ್ವದಲ್ಲಿರುವ ಔಷಧಿಗಳು ತಮ್ಮ ಪರಿಣಾಮವನ್ನು ಕಳೆದುಕೊಳ್ಳಲು ಪ್ರಾರಂಭಿಸುತ್ತವೆ ಮತ್ತು ಚಿಕಿತ್ಸೆ (Treatment) ಪಡೆಯಲು ಸಾಧ್ಯವಾಗುತ್ತಿಲ್ಲ.
Food Poisoning Remedies: ಫುಡ್ ಪಾಯಿಸನ್ ಸಮಸ್ಯೆಯೇ? ಮನೆಯಲ್ಲಿಯೇ ಈ ಔಷಧ ಮಾಡಿ
ಹಾಗಿದ್ರೆ ಈ ಡೇಂಜರಸ್ ಬ್ಯಾಕ್ಟಿರೀಯಾಗಳು ಎಲ್ಲೆಲ್ಲಿ ಇರುತ್ತವೆ. ಸಂದೇಹವೇ ಇಲ್ಲ, ಇವುಗಳೆಲ್ಲಾ ನಾವು ದಿನನಿತ್ಯ ಬಳಸೋ ವಸ್ತು, ಆಹಾರಗಳಲ್ಲೆಲ್ಲಾ ಸೇರಿಕೊಂಡಿರುತ್ತವೆ. ಅವು ಎಲ್ಲೆಲ್ಲಾ ಎಂಬುದನ್ನು ತಿಳಿದುಕೊಳ್ಳೋಣ.
ಇ.ಕೋಲಿ
ಸಿಡಿಸಿ ಪ್ರಕಾರ, ಎಸ್ಚೆರಿಚಿಯಾ ಕೋಲಿಯನ್ನು ಇ.ಕೋಲಿ ಎಂದೂ ಕರೆಯುತ್ತಾರೆ. ಈ ಬ್ಯಾಕ್ಟೀರಿಯಾವು ಪರಿಸರ, ಆಹಾರ ಮತ್ತು ಮಾನವರು ಮತ್ತು ಪ್ರಾಣಿಗಳ ಕರುಳಿನಲ್ಲಿ ಕಂಡುಬರುತ್ತದೆ. ಅಧ್ಯಯನದ ಪ್ರಕಾರ ಭಾರತದಲ್ಲಿ ಹೆಚ್ಚಿನ ಸಾವುಗಳು ಇ.ಕೋಲಿ ಸೋಂಕಿನಿಂದ ಸಂಭವಿಸಿವೆ. ಕೆಲವು ವಿಧಗಳು ಅತಿಸಾರ, ಮೂತ್ರದ ಸೋಂಕುಗಳು (Urine infection) ಮತ್ತು ಶ್ವಾಸಕೋಶದ ಕಾಯಿಲೆಗಳಿಗೆ ಕಾರಣವಾಗುತ್ತವೆ.
ಎಸ್.ಆರಿಯಸ್
ಸ್ಟ್ಯಾಫಿಲೋಕೊಕಸ್ ಔರೆಸ್ ಗೆ ಎಸ್. ಈ ಬ್ಯಾಕ್ಟೀರಿಯಾವು ಮಾನವನ ಮೂಗು ಮತ್ತು ಚರ್ಮದ (Skin) ಮೇಲೆ ಇರುತ್ತದೆ. ಸಾಮಾನ್ಯವಾಗಿ ಈ ಬ್ಯಾಕ್ಟೀರಿಯಾ ಅಪಾಯಕಾರಿ ಅಲ್ಲ. ಆದರೆ ಇದು ತೀವ್ರವಾದಾಗ, ಇದು ಸೆಪ್ಸಿಸ್ನಂತಹ ಮಾರಣಾಂತಿಕ ಸ್ಥಿತಿಯನ್ನು ಉಂಟುಮಾಡಬಹುದು.
ಎ.ಬೌಮನ್ನೀ
ಅಸಿನೆಟೊಬ್ಯಾಕ್ಟರ್ ಬೌಮನ್ನಿಯನ್ನು A. ಬೌಮೇನಿಯನ್ ಎಂದು ಕರೆಯಲಾಗುತ್ತದೆ. ಈ ಬ್ಯಾಕ್ಟೀರಿಯಾವು ಅನೇಕ ಬ್ಯಾಕ್ಟೀರಿಯಾಗಳ ಗುಂಪಾಗಿದೆ. ಪರಿಸರದಲ್ಲಿ ಮಣ್ಣು, ನೀರು ಇತ್ಯಾದಿಗಳಲ್ಲಿ ಇರುತ್ತದೆ. ಈ ಬ್ಯಾಕ್ಟೀರಿಯಾವು ರಕ್ತ, ಮೂತ್ರ ವ್ಯವಸ್ಥೆ, ಶ್ವಾಸಕೋಶ ಮತ್ತು ಗಾಯಗಳಲ್ಲಿ ಸೋಂಕನ್ನು ಉಂಟು ಮಾಡುತ್ತದೆ.
Urine Infectionಗೆ ಸೋಂಕೋಂದೇ ಕಾರಣವಲ್ಲ, ಬೇರೆ ಬೇರೆ ಕಾರಣಗಳಿಂದ ಕಾಡಬಹುದು ಅನಾರೋಗ್ಯ
ಎಸ್.ನ್ಯುಮೋನಿಯಾ
ರು. ನ್ಯುಮೋನಿಯಾದ ಪೂರ್ಣ ಹೆಸರು ಸ್ಟ್ರೆಪ್ಟೋಕೊಕಸ್ ನ್ಯುಮೋನಿಯಾ. ಈ ಬ್ಯಾಕ್ಟೀರಿಯಾವು ಉಸಿರಾಟದ ವ್ಯವಸ್ಥೆಯ ಮೇಲಿನ ಪದರದ ಮೇಲೆ ಇರುತ್ತದೆ. ಈ ವೈರಸ್ನಿಂದ ಉಂಟಾಗುವ ಸೋಂಕನ್ನು ನ್ಯುಮೋಕೊಕಲ್ ಸೋಂಕು ಎಂದು ಕರೆಯಲಾಗುತ್ತದೆ. ಇದು ಸಾಮಾನ್ಯವಾಗಿ ಮಕ್ಕಳನ್ನು (Children) ಹೆಚ್ಚು ಬಲಿಪಶುಗಳನ್ನಾಗಿ ಮಾಡುತ್ತದೆ.
ಕೆ-ನ್ಯುಮೋನಿಯಾ
ನ್ಯುಮೋನಿಯಾ ಎಂದು K. ಗೆ ಕ್ಲೆಬ್ಸಿಯೆಲ್ಲಾ ನ್ಯುಮೋನಿಯಾ. ಈ ಬ್ಯಾಕ್ಟೀರಿಯಾವು ಆರೋಗ್ಯವಂತ ಜನರ ಕರುಳು ಮತ್ತು ಮಲದಲ್ಲಿ ಇರುತ್ತದೆ. ಅಲ್ಲಿ ಅದು ಯಾವುದೇ ಸಮಸ್ಯೆಗಳನ್ನು ಉಂಟುಮಾಡುವುದಿಲ್ಲ. ಈ ಬ್ಯಾಕ್ಟೀರಿಯಂ ನ್ಯುಮೋನಿಯಾ, ರಕ್ತದ ಸೋಂಕು, ಶಸ್ತ್ರಚಿಕಿತ್ಸಾ ಸೈಟ್ ಸೋಂಕು, ಗಾಯದ ಸೋಂಕನ್ನು ಉಂಟುಮಾಡುತ್ತದೆ.